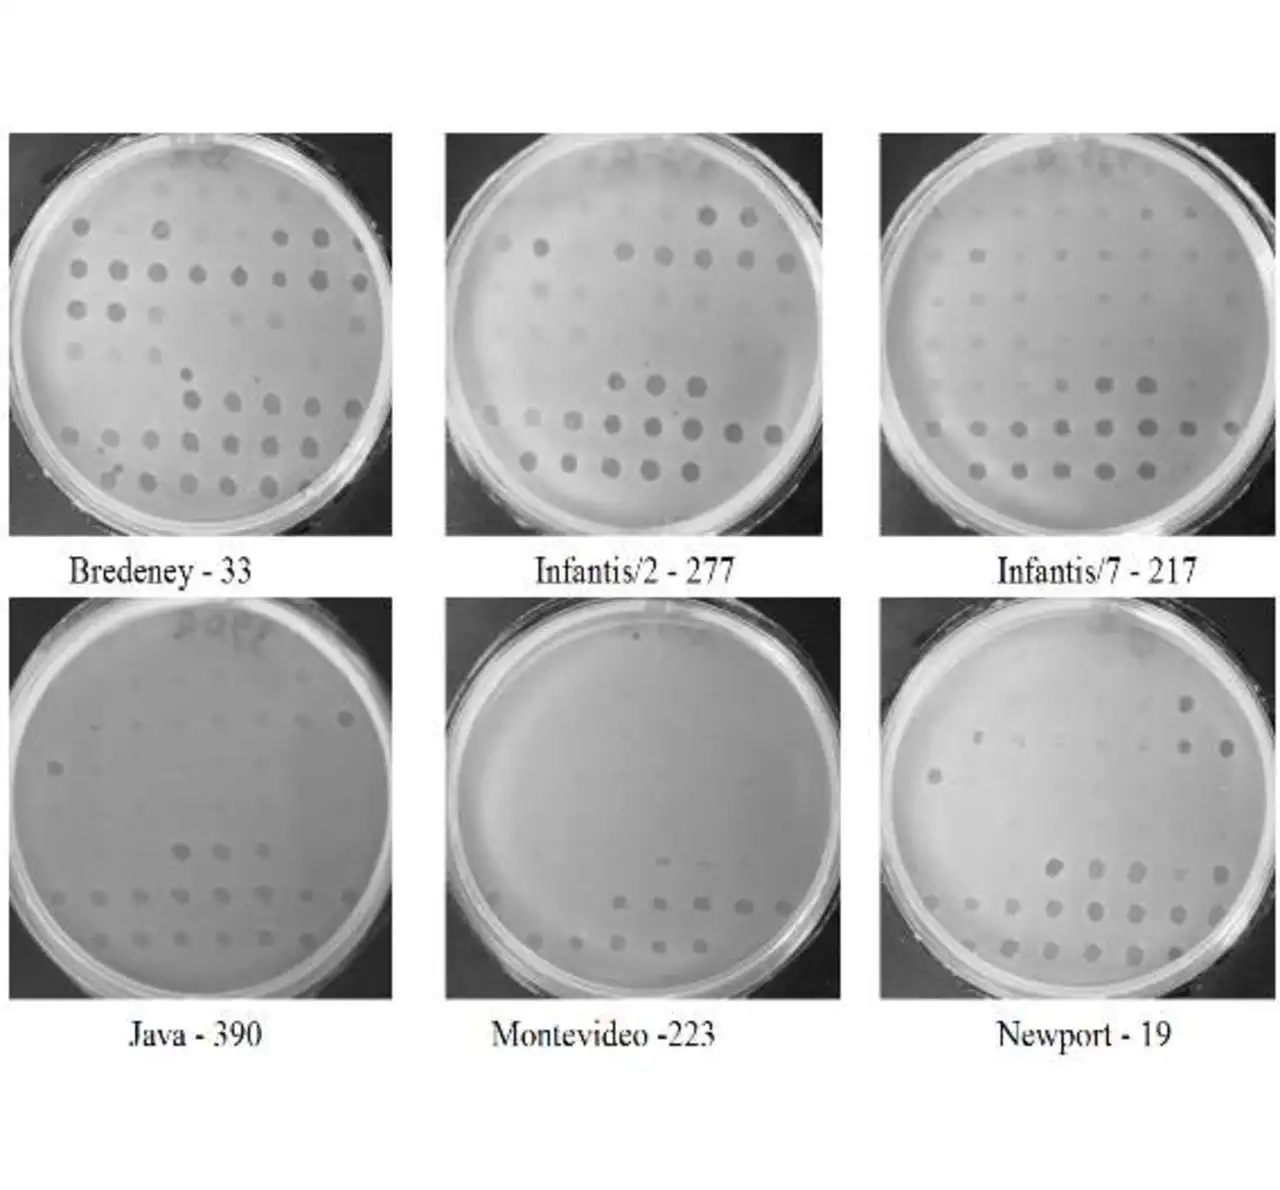

Impedanzspektroskopie identifiziert Erreger in Rekordzeit
Bakterieller Fingerabdruck
Elektrische Impedanzspektroskopie hat sich als Messverfahren in der Biotechnologie und Umwelttechnik etabliert - allerdings vor allem in wissenschaftlichen Labors. Industrielle An-wendungen waren selten, weil die nötige Messtechnik sehr kostenintensiv und schwer auf neue Anwendungen anpassbar war. Ein neues, modulares und skalierbares Hard- und Softwarekonzept ermöglicht nun Mehrkanal-Lösungen mit hohem Durchsatz, die zum Beispiel die eindeutige Bestimmung von Bakterientypen in kürzester Zeit erlauben.
Eine anwendungsspezifische Messlösung auf Basis der Impedanzspektroskopie war bisher nur über einen langwierigen und kostenintensiven Entwicklungsprozess realisierbar, der frühestens nach einigen Monaten ein erstes grobes Funktionsmuster hervorbrachte und unter Umständen viele Entwicklungszyklen mit immer neuen teuren Prototypen und zeitlich aufwändigen Tests umfasste.
Mit dem hier vorgestellten modularen Konzept (siehe Kasten) lassen sich innerhalb weniger Wochen Funktionsmuster zur Verfügung stellen, deren Einzelkomponenten allesamt bereits auf Funktionsweise und Zusammenspiel ausführlich getestet sind. Die Anzahl der notwendigen Entwicklungszyklen und damit die Entwicklungskosten auch für hochgradig spezialisierte Applikationen werden so auf ein Minimum reduziert. Viele Anwendungen der bisher meist rein wissenschaftlich genutzten Verfahren rund um die Impedanzspektroskopie werden so überhaupt erst denkbar.
Fallbeispiel bakterielle Fingerprints
Jobangebote+ passend zum Thema

In der Forschung seit langem etabliert sind Anwendungen der Impedanzspektroskopie auf Mikroelektrodenstrukturen für die Überwachung von Zellkulturen. Sciospec entwickelte hierfür ein spezielles Frontend mit integriertem 60-Kanal-Multiplexer, das »MEA«-Rack (Bild 1), mit dem sich verschiedenste Arten von Biochips für die Impedanzspektroskopie einfach nutzen lassen.
Im Rahmen einer internationalen Kooperation mit Dr. Gabriel Teper von der Hebrew University of Jerusalem kommt die Technik nun in einem vielversprechenden Projekt zum Einsatz mit dem Ziel, Salmonellenbefall in israelischem Geflügel einzudämmen. Der Nachweis basiert auf Bakteriophagen-Bibliotheken, mit denen sich nicht nur Gruppen von Bakterien unterscheiden lassen - die Technik erlaubt sogar eine Diskriminierung zwischen einzelnen Subtypen mit epidemiologisch wichtigen spezifischen Eigenschaften wie geographische Ausbreitung, Wirtsabhängigkeiten, Virulenz oder Resistenz gegenüber Antibiotika.
Damit ist dieses Verfahren Alternativen wie »Pulsed-phase Gel Electrophoresis« weit überlegen. Die Markerbibliothek besteht aus 240 verschiedenen Elementen, die an spezifischen Stellen eines Bakteriums anbinden können. Je nach Eigenschaften eines bestimmten Bakterien-Subtyps sind andere Kombinationen dieser Bindestellen vorhanden, also andere Marker dafür sensitiv. Auf der Basis dieser Empfindlichkeiten lässt sich nun für verschiedene Subtypen von Bakterien eine Art »Fingerabdruck« erzeugen, der eine eindeutige Unterscheidung ermöglicht.
Mit einer entsprechenden Visualisierungsmethode, der von Dr. Teper entwickelten »Pseudo Coloring Matrix«, entstehen leicht lesbare »Fingerabdrücke«. Für diese Anwendung wurden spezielle, mit dem MEA-Rack kompatible Mikroelektrodenstrukturen gefertigt (Bild 2). Da keine schnellen Messzyk-len notwendig sind, führt ein 64-Kanal-Multiplexer die verschiedenen Elektroden nacheinander an ein Präzisions-Frontend, dessen Bandbreite und Dynamikumfang für die Messung von kΩ bis MΩ und von 1 mHz bis 1 MHz optimiert sind - genau der Bereich, in dem die Detektionsmechanismen der Marker wirksam werden.

In einem nächsten Schritt ist geplant, die Elektrodenstrukturen in eine Multisensorplattform zu integrieren, die dann mit einem einzigen Prozessschritt in einer Probe das vollständige Screening über alle 240 Marker vollautomatisch ausführt. Der Anwender wird damit in der Lage sein, die vorhandenen Bakterien anhand beispielsweise eines Nasenabstriches schnell und ohne weitere Probenvorbereitung zu identifizieren. Diese Art der Untersuchung eignet sich somit auch als »Point-of-Care«-Diagnostik, also direkt vor Ort beim Patienten.
Chancen dieser Technologie liegen nicht nur in der zunächst angestrebten Eindämmung des Salmonellenbefalls in der israelischen Geflügelindustrie sondern auch in klinischen Anwendungen. Die Markerbibliothek lässt sich entsprechend erweitern und umfasst bereits jetzt für die Epidemiologie wichtige Bakterientypen wie »Staphylococcus aureus«. Da gerade im Krankenhausbereich multiresistente Keime wie »MRSA« in den letzten Jahren immer mehr als Gesundheitsproblem in den Fokus der Öffentlichkeit geraten sind, liegen die Vorteile eines einfachen, kostengünstigen Screening-Verfahrens auf der Hand.
Durch eine breite Erfassung des Auftretens verschiedener Subtypen von Erregern, gepaart mit einer möglichen zentralen Datenbankstruktur mit bakteriellen Fingerabdrücken, wird das Verfolgen der globalen Verbreitung und Entwicklung beispielsweise von Arzneimittelresistenzen bei Keimen im Vergleich zur heutigen Praxis stark vereinfacht. Gerade im klinischen Bereich eröffnen sich so ganz neue Möglichkeiten der frühzeitigen Erkennung und gezielten Behandlung.
Es müssen nicht zwangsläufig breitbandige Antibiotika zum Einsatz kommen, sondern eine gezielte Auswahl von Arzneimitteln ist möglich. So lässt sich langfristig auch die Weiterentwicklung von multiresistenten Erregern vermeiden. Und das Verfahren könnte sich in Zukunft sogar für die gezielte Eindämmung potenziell gefährlicher Subtypen eignen.
| Modulares Systemkonzept |
|---|
|
Um mit einem Konzept möglichst alle Anwendungen der elektrischen Impedanzspektroskopie bedienen zu können, müssen sowohl hohe Auflösungen, große Messbereiche und Präzision als auch kostenoptimierte Mehrkanallösungen realisierbar sein. Als Lösungsansatz entstand ein alle Systemebenen umspannendes Modulkonzept, das sich in jedem Abschnitt der Signalkette anpassen läst und eine Skalierung des Messsystems ermöglicht. Neben analoger und digitaler Hardware beinhaltet diese Modulstruktur auch Embedded-Software im klassischen Sinne (ohne Betriebssystem), Java-Software auf Betriebssystembasis, Treiber für eine Embedded-Linux-Plattform auf »ARM«-Basis und den FPGA-Schaltungsentwurf. Große Teile der Module sind leicht austauschbar, um auf verschiedene Applikationsanforderungen zu reagieren. So ist beispielsweise ein analoges Frontend für Mehrkanal-Zellimpedanzspektroskopie mithilfe von Multi-Elektroden-Arrays verfügbar, aber ebenso ein einfaches Einkanal-Frontend mit BNC-Anschlüssen für den Laborbetrieb. Nicht nur in der Hardware sondern auch in der Steuerungsalgorithmik, Signalverarbeitung und Datenauswertungssoftware lassen sich Module den Anforderungen entsprechend austauschen. Diese Modularität, die sich durch das gesamte Systemkonzept zieht, ist der Kernpunkt des flexiblen Systemdesigns. Zusammenstellungen der Module ergeben eine anwendungsspezifische Messlösung, die sich durch die Kombination mit einem Speicher- und Steuerungsknoten auf ARM-Basis auf fast beliebige Kanalanzahl erweitern lässt. Auch verteilte Netzwerklösungen beispielsweise für die Prozess- und Qualitätsüberwachung in Industrieanlagen sind damit leicht umsetzbar. Das Herz des Systems ist eine für hohen Datendurchsatz optimierte FPGA-Steuerungsplattform. Abhängig von den konkreten Anforderungen der Anwendung fungiert diese entweder ausschließlich als Kommunikationsknoten zwischen Messsystem und der Steuerungs- und Kontrollsoftware auf dem PC oder beinhaltet neben der Prozesssteuerung auch Datenverarbeitung und -analyse, Fehlerkorrektur und Datenmanagement, womit das System unabhängig arbeiten kann. Als Schnittstelle zum Nutzer steht eine Java-Softwareplattform zur Verfügung, die entweder auf einem PC oder auf der Embedded-Linux-Plattform in einem Messgerät integriert läuft. Damit lassen sich Messgeräte bedienen und Daten analysieren - über Maus und Tastatur, einem in das Gerät integrierten Touchpanel oder über Kommunikationsprotokolle auf TCP/IP-Basis. Neben der Konfiguration der Messgeräte und vielfältigen Darstellungs- und Datenexportmöglichkeiten für die aufgenommenen Messdaten sind auch erweiterte Analysen wie Filterung, Parameterfitting oder statistische Auswerung integriert. |